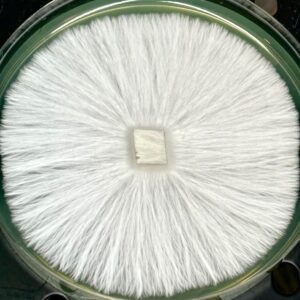

agar dish
Showing 1–32 of 105 resultsSorted by latest
-
See more products by: BioTron Genetics
Yeti Research Plate – 100mm
$20.00 -
See more products by: BioTron Genetics
-
See more products by: BioTron Genetics
-
See more products by: BioTron Genetics
TAT Research Plate – 100mm
$20.00 -
See more products by: BioTron Genetics
-
See more products by: BioTron Genetics
-
See more products by: BioTron Genetics
-
See more products by: Chasing Chaos Genetics
-
See more products by: BF Genetics
-
See more products by: Blue Bear Mycology
Tattoo Research Plate
$25.00 -
See more products by: Blue Bear Mycology
-
See more products by: Basement Culture
-
See more products by: Basement Culture
-
See more products by: Basement Culture
-
See more products by: ClemGrows
Agar Quad-Stack Mini (for 60-70mm plastic dishes)
Original price was: $45.00.$35.00Current price is: $35.00. -
See more products by: RockyMountainFamilyMycology
(5) Pre poured 100mm Cell Treat Petri Dishes W/ Grip Ring
Original price was: $15.00.$8.99Current price is: $8.99. -
See more products by: Blue Bear Mycology
Whitebilly Research Plate
$25.00 -
See more products by: Blue Bear Mycology
-
See more products by: Blue Bear Mycology
Yellow Umbo Research Plate
$25.00 -
See more products by: The Fungus Frequency
5 – 100mm MEY Agar Plates
$12.50 -
See more products by: The Fungus Frequency
1 – 100mm MEY Agar Plate
$3.00 -
See more products by: Blue Bear Mycology
Coda Research Plate
$20.00 -
See more products by: Blue Bear Mycology
Golden Envy Research Plate
$20.00 -
See more products by: Blue Bear Mycology
Z Strain Research Plate
$20.00 -
See more products by: Blue Bear Mycology
Ski Bum Research Plate
$20.00 -
See more products by: Humble Bruise
DC MAK Research Plate
$23.50 -
See more products by: Humble Bruise
-
See more products by: Humble Bruise
-
See more products by: Humble Bruise
Maria Sabina Research Plate
$23.50 -
See more products by: Blue Bear Mycology
Tex APE6 Research Plate
$20.00 -
See more products by: Humble Bruise
Melmak Research Plate
$23.50 -
See more products by: Humble Bruise
Goliath PE Research Plate
$23.50